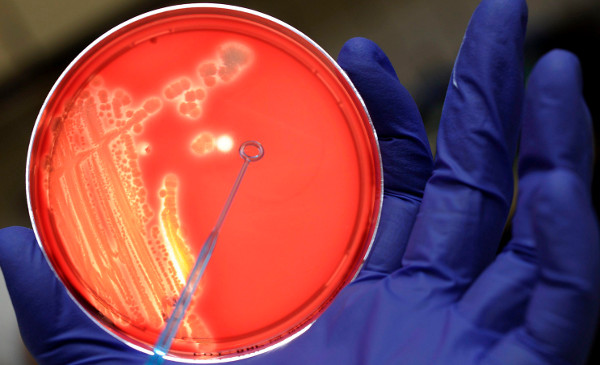

1. Día Internacional del Orgullo LGTB, 9 claves para una buena redacción
El 28 de junio se celebró el Día Internacional del Orgullo LGTB. Esta recomendación, en la que recogemos expresiones y términos relacionados, ha sido la recomendación más vista de las publicadas este mes.

Foto: ©Archivo EFE/Lucas Dolega
2. patología no es sinónimo de enfermedad
En la FundéuRAE detectamos que, en ocasiones, se emplea patología como equivalente de enfermedad. Por este motivo, decidimos explicar la diferencia entre ambos términos y que, aunque en el uso general es posible utilizarlos como sinónimos, en el especializado conviene diferenciarlos.
Foto: ©Archivo EFE/Marius Becker
3. staff, anglicismo innecesario
El extranjerismo staff tiene alternativas en español, y en la tercera recomendación más vista de este mes ofrecemos algunas en función del contexto, como personal, plantilla, equipo directivo…

Foto: ©Archivo EFE/Alejandro García


